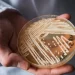
Infeksioni shkakton viktimën e parë në Itali, çfarë është “kërpudha vrasëse”?

Kryeministri Edi Rama ka reaguar në lidhje me tensionet e regjistruar në Veri të Kosovës. Nëpërmjet një postimi në rrjetet sociale, Rama bën apel për qetësim të situatës.
Kreu i qeverisë shprehet se tensionet nuk e ndihmojnë aspak procesin e normalizimit të marrëdhënieve dhe njohjes së ndërsjellë mes Kosovës dhe Serbisë.
Ai po ashtu sjell në vëmendje se ndërkombëtarët janë të shqetësuar për situatën e krijuar, nisur kjo edhe nga reagimet e tyre.
Rama thotë se bashkohet me apelin e tyre që dy vendet të mos ecin më në këtë drejtim “të panevojshëm”. Përkundrazi, shton ai, vëmendja duhet drejtuar te dialogu dhe njohja e ndërsjellë mes dy vendeve.
Reagimi i Ramës
A e ndihmon kjo që po ndodh në Kosovë procesin ku janë angazhuar të tërë miqtë e mëdhenj të Kosovës e të shqiptarëve, për normalizim dhe njohje të ndërsjellë mes Kosovës dhe Serbisë?! Me siguri jo përderisa vetë miqtë tanë më të mëdhenj shprehen thellësisht të shqetësuar! Unë bashkohem me ta në apelin për të mos ecur më tej në këtë shteg jo vetëm të rrezikshëm, po edhe krejt të panevojshëm sot, kur bota demokratike e ka vendosur në qendër të vëmendjes dialogun, normalizimin, njohjen e ndërsjellë mes Kosovës dhe Serbisë.